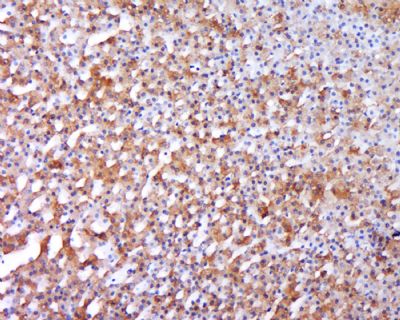

产品中心
当前位置:首页>产品中心Anti-BMP1
货号: bs-6401R 基本售价: 1380.0 元 规格: 100ul
- 规格:100ul
- 价格:1380.00元
- 规格:200ul
- 价格:2200.00元
产品信息
- 产品编号
- bs-6401R
- 英文名称
- BMP1
- 中文名称
- 骨形态发生蛋白1/胶原C蛋白肽链内切酶抗体
- 别 名
- BMP 1; BMP-1; Bone morphogenetic protein 1; Mammalian tolloid protein; mTld; PCOLC; PCP; ProCollagen C endopeptidase; Procollagen C proteinase; TLD; BMP1_HUMAN.
- 规格价格
- 100ul/1380元购买 200ul/2200元购买 大包装/询价
- 说 明 书
- 100ul 200ul
- 研究领域
- 细胞生物 免疫学 信号转导 细胞骨架 细胞外基质
- 抗体来源
- Rabbit
- 克隆类型
- Polyclonal
- 交叉反应
- Human, Mouse, Rat, Dog, Pig, Cow, Horse, Rabbit,
- 产品应用
- WB=1:500-2000 ELISA=1:500-1000 IHC-P=1:400-800 IHC-F=1:400-800 IF=1:100-500 (石蜡切片需做抗原修复)
not yet tested in other applications.
optimal dilutions/concentrations should be determined by the end user.
- 分 子 量
- 98kDa
- 细胞定位
- 细胞浆 细胞外基质 分泌型蛋白
- 性 状
- Lyophilized or Liquid
- 浓 度
- 1mg/ml
- 免 疫 原
- KLH conjugated synthetic peptide derived from human BMP1:901-986/986
- 亚 型
- IgG
- 纯化方法
- affinity purified by Protein A
- 储 存 液
- 0.01M TBS(pH7.4) with 1% BSA, 0.03% Proclin300 and 50% Glycerol.
- 保存条件
- Store at -20 °C for one year. Avoid repeated freeze/thaw cycles. The lyophilized antibody is stable at room temperature for at least one month and for greater than a year when kept at -20°C. When reconstituted in sterile pH 7.4 0.01M PBS or diluent of antibody the antibody is stable for at least two weeks at 2-4 °C.
- PubMed
- PubMed
- 产品介绍
- background:
Bone morphogenetic protein 1 (BMP1) was first identified in osteogenic extracts of bone. It is an extracellular zinc endopeptidase, implicated in morphogenetic processes in a broad range of species. BMP1 is a member of the astacin family of metalloproteinases. The astacin family includes BMP1, astacin, meprin A and B, tolloid-like proteins, and choriolysin. BMP1 is involved in extracellular matrix (ECM) formation, suggesting that a functional link may exist between astacin metalloproteinases, growth factors, and cell differentiation and pattern formation during development. The name PCP reflects this enzyme’s involvement in the collagen deposition of growing bone. The enzymes known as the procollagen C and N proteinases (PCP and PNP) are involved in the processing of fibrillar procollagen precursors to mature collagens, which is an essential requirement for fibril formation. PCP cleaves the C-terminus from procollagen, to allow the formation of mature, triplehelical collagen. The N-terminus is cleaved by the procollagen N-proteinase (PNP or ADAM-TS2). Defects in PNP have been linked to the skin disorder dermatosparaxis, and defects in BMP1 are thought to lead to aberrant collagen processing, and connective tissue disorders. Many forms of BMP1 have been reported, with varying truncation at the C-terminus. The long form of BMP1 is most similar to the tolloid-like proteins, which have extra EGF-like and CUB domains.
Function:
Cleaves the C-terminal propeptides of procollagen I, II and III. Induces cartilage and bone formation. May participate in dorsoventral patterning during early development by cleaving chordin (CHRD).
Tissue Specificity:
Ubiquitous.
Similarity:
Belongs to the peptidase M12A family. Contains 5 CUB domains. Contains 2 EGF-like domains.
SWISS:
P13497
Gene ID:
649
Database links:Entrez Gene: 649 Human
Entrez Gene: 12153 Mouse
Entrez Gene: 83470 Rat
Omim: 112264 Human
SwissProt: P13497 Human
SwissProt: P98063 Mouse
Unigene: 1274 Human
Unigene: 27757 Mouse
Unigene: 9305 Rat
Important Note:
This product as supplied is intended for research use only, not for use in human, therapeutic or diagnostic applications.
- 产品图片
 Sample:
Sample:
Brain (Mouse) Lysate at 40 ug
Lung (Mouse) Lysate at 40 ug
Primary: Anti-BMP1 (bs-6401R) at 1/300 dilution
Secondary: HRP conjugated Goat-Anti-rabbit IgG (bs-0295G-HRP) at 1/5000 dilution
Predicted band size: 98 kD
Observed band size: 98 kD Sample: Liver (Mouse) Lysate at 40 ug
Sample: Liver (Mouse) Lysate at 40 ug
Primary: Anti-BMP1 (bs-6401R) at 1/300 dilution
Secondary: IRDye800CW Goat Anti-Rabbit IgG at 1/20000 dilution
Predicted band size: 98 kD
Observed band size: 98 kD Sample: Liver (Mouse) Lysate at 40 ug
Sample: Liver (Mouse) Lysate at 40 ug
Primary: Anti-BMP1 (bs-6401R) at 1/300 dilution
Secondary: HRP conjugated Goat-Anti-rabbit IgG (bs-0295G-HRP) at 1/5000 dilution
Predicted band size: 98 kD
Observed band size: 98 kD Tissue/cell: Rat adrenal gland; 4% Paraformaldehyde-fixed and paraffin-embedded;
Tissue/cell: Rat adrenal gland; 4% Paraformaldehyde-fixed and paraffin-embedded;
Antigen retrieval: citrate buffer ( 0.01M, pH 6.0 ), Boiling bathing for 15min; Block endogenous peroxidase by 3% Hydrogen peroxide for 30min; Blocking buffer (normal goat serum,C-0005) at 37℃ for 20 min;
Incubation: Anti-BMP1 Polyclonal Antibody, Unconjugated(bs-6401R) 1:500, overnight at 4°C, followed by conjugation to the secondary antibody(SP-0023) and DAB(C-0010) staining

